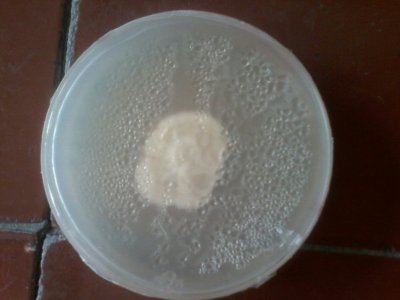
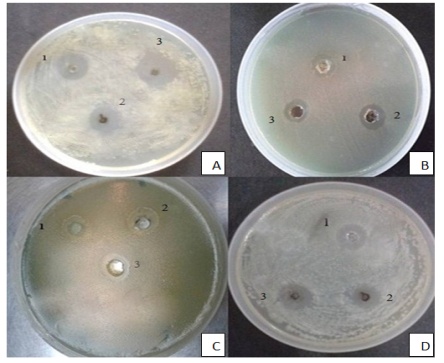
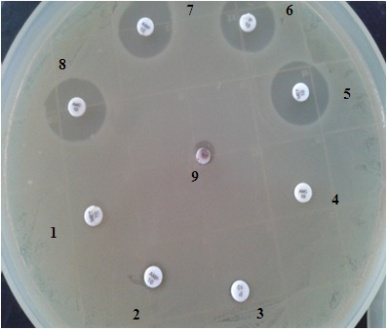
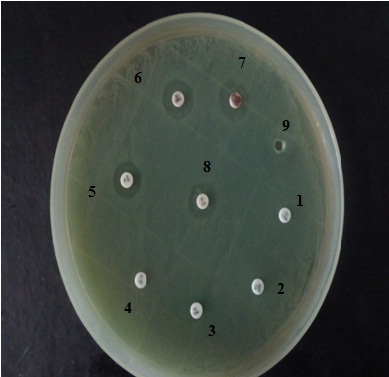
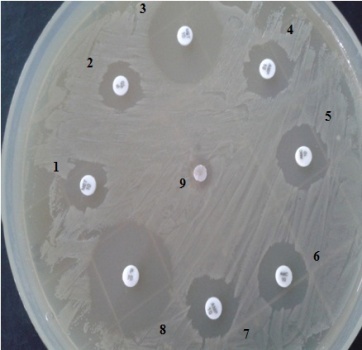

Int J Pharm Pharm Sci, Vol 6, Issue 11, 160-166Original Article
BIOSYNTHESIS OF SILVER NANOPARTICLES FROM FUNGAL ROOT ENDOPHYTES OF SIDA ACUTA PLANT AND EVALUATION OF THEIR ANTIBACTERIAL AND ANTIBIOTIC ENHANCING ACTIVITY
DEEPAK K. RAHI, ARUNA S. PARMAR, VISHAL TIWARI
Department of Microbiology, Panjab University, Chandigarh 160014
Email: deepakrahi10@rediffmail.com
Received: 02 Jul 2014 Revised and Accepted: 05 Aug 2014
ABSTRACT
Objectives: Biosynthesis of silver nanoparticles has received much attention in recent years due to their numerous advantages over physical and chemical synthesis like being eco friendly, free from hazardous chemicals etc. Large number of biological agents are used for the biosynthesis of metal nanoparticles including plants and microbes. Amongst microbes fungi are better candidates for biosynthesis of various metal nanoparticles owing to certain physiological, morphological and metabolical characteristics. Further amongst fungi, the potential of endophytic fungi for the biosynthesis of metal nanoparticles has been less explored. Therefore, in present communication, the two important endophytic fungi isolated from Sida acuta (Wire weed) plant have been screened out for their potential to synthesize silver nanoparticles. The synthesized silver nanoparticles was further evaluated for antibacterial and antibiotic enhancing activity.
Methods: The fungal root endophytes isolated from Sida acuta plants were identified by studying morphological and microscopical characterstics and were keyed out to their respective genus by consulting relevant literature. The silver nanoparticle synthesizing potential of the isolated fungal endophytes was observed visually and confirmed by UV/Visible spectroscopical analysis under the wavelength range of 380-680 nm. These silver nanoparticles were further characterized by transmission electron microscopy (TEM), particle size analyzer (PSA) and Fourier transform infrared spectroscopy (FTIR) analysis. In addition, their antibacterial and antibiotic enhancing activities against four standard bacterial pathogens (Escherichia coli, MRSA, Pseudomonas aeruginosa and Staphylococcus aureus) were also evaluated as per the standard disk diffusion method.
Results: The two fungal root endophytes were isolated from Sida acuta plant and were identified as the species of Syncephalis and Geotrichum. Both these species were capable of synthesizing the silver nanoparticles as observed by the change in colour of the reaction mixture from transparent to dark brown and was confirmed by UV/Visible spectroscopy by observing the peaks of silver nanoparticles in the wavelength range of 380-680 nm. TEM analysis and study performed with particle size analyser revealed the silver nanoparticle synthesized by both the species varied in size and were mostly spherical in shape. While the FTIR analysis indicated the involvement of different functional groups in the silver nanoparticles synthesis by both the species. Besides, the synthesized silver nanoparticles was found to possess potential antimicrobial activity and was also capable of enhancing the efficiencies of some commercial antibiotics.
Conclusion: The fungal root endophytes, Syncephalis and Geotrichum isolated from plant Sida acuta were capable of synthesizing silver nanoparticles with remarkable antibacterial and antibiotic enhancing properties.
Keywords: Sida acuta, Silver nanoparticles, Endophytic fungi, TEM, PSA, FTIR, Antibacterial, Antibiotic enhancer.
INTRODUCTION
Nanotechnology is the technology by which we can manipulate the properties of matter at the nanoscale level. Properties of nanomaterials are different from their bulk counterparts as a result of which they can be used in many industries [1]. These can be synthesized by number of ways including physical, chemical and biological methods [2]. In the recent years biological method has gained much attention due to certain properties like being an eco friendly way of synthesis, free from hazardous chemicals etc. Among biological methods, much of the work has been done on plants, plant products, extracts etc. However, microorganisms like bacteria and fungi particularly the endophytic fungi have been explored very less despite having equal potential to synthesize various metal nanoparticles [3]. Endophytes can be defined as the microbes which reside inside the plant tissues asymptomatically without being pathogenic to the host [4]. These endophytes produce certain compounds either intracellularly or extracellularly which causes reduction of silver nitrate to silver nanoparticles [5]. Therefore, in the present investigation an attempt has been made to biosynthesize the silver nanoparticles using two important endophytic fungal organisms isolated from the roots of Sida acuta plant.
MATERIALS AND METHODS
Isolation and identification of fungal root endophytes
The sample of Sida acuta plant for isolation of fungal root endophytes was obtained from medicinal garden of Panjab University, Chandigarh, India. The isolation of fungal endophyte/s from root of the plant was made as per Hallman et al [6]. In this method the root samples of Sida acuta plant were first washed under running tap water to remove any dust or debris attached to it. After that the samples were immersed in 70% ethanol for 1 minute and then in sodium hypochloride solution (4%) (v/v) for 4 minutes. Samples were again rinsed with 70% ethanol for 1 minute and finally rinsed with sterilized distilled water to remove the sterilants used and blot dried on sterile blotting paper. The sterilized root samples were cut into small pieces (about 1-2 cm) by sterilized scalpel and inoculated in Petri plates containing potato dextrose agar medium (PDA) supplemented with chloramphenicol. A control was also maintained in the same plate to observe the appearance of probable epiphytes. This was done by making the imprints of root parts parallel to the ‘test inoculation’ on the agar surface. The absence of any epiphytic growth in the imprint region indicated that the sterilization method was effective. The plates were then incubated at 28±0.50C and monitored every day for the appearance of endophytic fungal growth. The successfully isolated fungal root endophytes was numbered as SRE7 and SRE8 and were identified as per Tieghem & Le Monnier [7] and Kurtzman & Fell [8] respectively on the basis of studies made on morphological and microscopical characteristics and by consulting relevant literature.
Biosynthesis of silver nanoparticles
The biosynthesis of silver nanoparticle was done as per method of Hemanth et al [9]. In this method, the required fungal biomass was cultivated by growing the fungal root endophytes in 250 ml flask containing 100 ml of potato dextrose broth (PDB) separately, incubated at 28±0.5ºC for 7 days under shaking. After incubation, the fungal biomass was harvested either by filtration or centrifugation (at 10,000 rpm for 10 minutes). The pellets of fungal biomass so obtained were washed 3-4 times with water to remove any attached media components. 10 gm of this mycelial biomass was suspended in 100 ml sterilized water in 250 ml flask, incubated at 28±0.5ºC, for 3 days under shaking. After that, the mycelial biomass was separated from the water by filtering and the cell filtrate was used further for the biosynthesis of silver nanoparticles.
The reduction reaction for biosynthesis of silver nanoparticle was carried by adding 0.5 ml of 0.1M silver nitrate in 49.5 ml of cell filtrate so as to get the 1 mM volume as the final concentration of silver nitrate in the reaction mixture. A control containing cell filtrate without silver nitrate was also maintained under the same conditions. The formation of silver nanoparticles was monitored visually by observing the change of colour in the reaction mixture (i. e., colour change from colourless/yellow to dark brown) and also by UV/Visible spectrophotometry under the wavelength scan of 200-800 nm.
Characterization of silver nanoparticles
The characterization of size, shape and dispersity of mycosynthesized silver nanoparticles was done by analyzing the nanoparticles by transmission electron microscopy (TEM) and particle size analyzer (PSA). The presence of various functional groups was analyzed by fourier transform infrared spectroscopy (FTIR).
Evaluation of antibacterial activity of silver nanoparticles
Antibacterial activity of biosynthesized silver nanoparticles was studied as per agar diffusion method of Midolo et al [10]. The antibacterial activity was evaluated against standard bacterial pathogens, Escherichia coli, Methicillin resistant Staphylococcus aureus (MRSA), Pseudomonas aeruginosa and Staphylococcus aureus. In this method, the test bacterial pathogens were first inoculated on nutrient agar by the spread plate method. The wells were made by sterile borer on the nutrient agar plates and loaded with 15 µl of silver nanoparticles under aseptic conditions and incubated for 24 hrs at 37ºC. The formation of zone of inhibition (if any) was observed after 24 hrs and expressed in millimeters (mm). The percentage inhibition was also calculated using the formula:

where, ‘t’ = zone of inhibition obtained by placing disc coated with silver nanoparticles and
‘c’ = zone of inhibition obtained by placing disc coated with silver nitrate solution.
Evaluation of antibiotic enhancing activity of silver nanoparticles
Antibacterial enhancing activity of biosynthesized silver nanoparticles in combination with some important commercial antibiotics was also evaluated as per disk diffusion method of Bauer et al [11]. In this method, the standard antibiotic discs (Penicillin, Methicillin, Ampicillin and Amoxicillin) with concentration 10µg each were impregnated with biosynthesized silver nanoparticles (10 µl) and placed on nutrient agar plate pre-inoculated with bacterial test pathogens (Escherichia coli, MRSA, Pseudomonas aeruginosa and Staphylococcus aureus) and incubated at 37°C for 24 hrs. The formation of zone of inhibition (if any) was observed and measured in millimeters and compared with control i. e., disc with silver nitrate only and antibiotic discs without silver nanoparticles. The increase in fold area was assessed as per Birla et al [12] by calculating the mean surface area of the zone of inhibition of each antibiotic (A) and antibiotic + silver nanoparticle (B) using the formula (B2-A2)/A2 where ‘A’ and ‘B’ were zones of inhibition for antibiotic and antibiotic + silver nanoparticles respectively. In case of absence of zone of inhibition of ‘[A]’, the standard diameter of antibiotic disc itself (6 mm) was considered as the zone as per Birla et al [12].
RESULTS AND DISCUSSION
Isolation and identification of fungal root endophytes
The endophytic fungal cultures which were isolated from the root samples of the plant Sida acuta were identified as the species of Syncephalis and Geotrichum by studying various morphological and microscopical characteristics and consulting relevant literature (Table 1-2; Fig. 1).
Biosynthesis of silver nanoparticles
The biosynthesis of silver nanoparticles by the endophytic fungi was evaluated visually by observing the change of colour of reaction mixture from transparent/yellowish to dark-brown which was due to the reduction of silver ions to silver nanoparticles (i. e., Ag+ to Ag0) (Figure 2). The biosynthesis of silver nanoparticles was also assessed by UV/Visible spectroscopical analysis of the reaction mixture by observing peak of the biosynthesized silver nanoparticles in the range of 380-680 nm which is the defined range of the silver nanoparticles (Figure 3-4). It was observed that with increase in time, there was increase in absorption peak which ultimately showed the increase in concentration of silver nanoparticles with time. Biosynthesis of silver nanoparticles was indicated by the peaks obtained in 380-680 nm due to surface plasmon resonance.
Table 1: Morphological and microscopical characteristics of Syncephalis species isolated from roots of Sida acuta plant.
Morphological characteristics |
|||||
Colony |
Size |
Shape |
Texture |
Colour |
|
On PDA: diffused |
Up to 2 cm in diameter |
Irregular, radial, flat; margin entire |
Rough, dry |
Grayish black at the centre, yellowish periphery, turning grey at maturity |
|
Microscopic characteristics |
|||||
Merospores |
Merosporangia |
Sporophores |
Hyphae |
||
Present as doliiform shaped |
Present on sporophores emerges as papillae which gradually elongated to form long, thin cylindrical outgrowths (30.0-36.0 µm). |
Simple, undivided, radiating from the head of the mature sporophores |
Hyaline, double walled |
||
Table 2: Morphological and microscopical characteristics of Geotrichum species isolated from roots of Sida acuta plant.
Morphological characteristics |
|||||
Colony |
Size |
Shape |
Texture |
Colour |
|
On PDA plate, aggregated. |
2-3 cm in diameter |
Irregular, slightly elevated at the centre |
Rough, dry, margin entire |
White to cream coloured |
|
Microscopic characteristics |
|||||
Arthroconidia |
Hyphae |
||||
7.2-10.0 x 3.0-5.5 µm, unicellular, in chains, hyaline, usually rounded, few rectangular |
Fragmented hyphae obtained from undifferentiated hyphae by fission of the filament. Abundant true mycelium observed, 4.0-6.5 µm wide |
||||
  |
|
 |
Fig. 1: A) The host Sida acuta plant; B): Pure culture of endophytic Syncephalis sp. isolated from the roots of Sida acuta plant; C): Microscopic fructification of Syncephalis sp.; D): Culture of endophytic Geotrichum sp. isolated from the roots of Sida acuta plant; E): Microscopic image of Geotrichum sp.

Fig. 2: Change in colour of reaction mixture from transparent (control) (C) to brown (Test) (T), indicating the biosynthesis of silver nanoparticles on 5th(144 hrs) of incubation by (A) Syncephalis sp. and (B) Geotrichum sp.

Fig. 3: Peaks of silver nanoparticles synthesized by Syncephalis sp. after 24, 48, 72, 96, 120 and 144 hrs obtained by UV/Visible spectroscopical analysis.

Fig. 4: Peaks of silver nanoparticle synthesized by Geotrichum sp. after 24, 48, 72, 96, 120 and 144 hrs obtained by UV/Visible spectroscopical analysis.
Characterization of silver nanoparticles by TEM
The characterization of biosynthesized silver nanoparticles by TEM revealed the polydisperse nature of the nanoparticles. Nanoparticles synthesized by Syncephalis sp. varied in size from 6.40 nm to 16.9 nm (Figure 5) where as the nanoparticles of Geotrichum sp. were found in the range of 3.63 nm to 14.2 nm (Figure 6). However, in both the cases shape was found to be mostly spherical.

Fig. 5: TEM of silver nanoparticles synthesized by Syncephalis sp. showing variable size range.
Characterization of silver nanoparticles by FTIR
FTIR analysis of the silver nanoparticles gives us information about the chemical bonds and molecular structures of possible compounds that could play an important role in the formation and stability of nanoparticles [13]. Peak obtained in the FTIR spectra of nanoparticles by Syncephalis sp. (Figure 7) at 1650 cm-1is due to C=O stretch vibrations and at 1436 cm-1due to N-H stretch vibrations while their corresponding stretching vibrations were seen around 3300 and 2900 cm-1 respectively. Peak around 1047 cm-1 can be assigned to the C–N stretching vibrations of the aliphatic amines (Figure 7).

Fig. 6: TEM of silver nanoparticles synthesized by root endophytic Geotrichum sp. showing variable size range.
Peak obtained in the FTIR spectra of nanoparticles by Geotrichum sp. (Figure 8) at 1646 and 1437 cm-1, it is due to stretch vibrations of –C=O and N-H groups respectively. Peak around 2900 cm−1 can be assigned to the stretching vibrations of secondary amines. While peaks in the region of 3400 cm-1can be assigned to O-H stretching of alcohol This indicated the involvement of different compounds and functional groups in silver nanoparticle biosynthesis.

Fig. 7: FTIR of silver nanoparticles synthesized by root endophytic species of Syncephalis.
Characterization of silver nanoparticles by Particle Size Analyser (PSA)
Particle size analysis of silver nanoparticles was performed using Malvern Hydro 2000S particle size analyzer. The principle of particle size analyzer is that when a focused laser beam is passed through the particle preparation, the particles scatter the light at angles inversely proportional to their size. The map of scattering intensity versus angle is the primary source of information used to calculate the particle size. The result obtained revealed that 10% particles of the total population of nanoparticles biosynthesized by both the species i. e., Geotrichum and Syncephalis were less than 72 nm (i. e. d(0.1)=72 nm). The median size of the nanoparticle population was found to be 92 nm for Syncephalis 88 nm for Geotrichum species. Variation in the size of the nanoparticles synthesized by both the species is clearly displayed in figure 9 and 10. This was also revealed by TEM analysis. Thus, the present fungal isolates have the potential to biosynthesize silver nanoparticles of a varying size range which may find multifarious applications in medical field.

Fig. 8: FTIR of silver nanoparticles synthesized by root endophytic species of Geotrichum.
Antibacterial activity of biosynthesized silver nanoparticles
The antibacterial activity of the biosynthesized silver nanoparticles was determined by agar diffusion method. It was measured as the size (diameter) of the zone of inhibition in mm and their percentage inhibition was also calulated (Table 3). The bigger the zone of inhibition, the higher the antibacterial activity. The result obtained revealed that the silver nanoparticles were quite effective in inhibiting the growth more or less of all the test bacterial strains. However, the maximum inhibitory activity of silver nanoparticles produced by Syncephalis species was found against Staphylococcus aureus (50%) while in case of Geotrichum species it was found against Escherichia coli (80%) (Figure 11).
 .
.
Fig. 9: Particle size analysis of silver nanoparticles synthesized by root endophytic species of Syncephalis

Fig. 10: Particle size analysis of silver nanoparticles synthesized by root endophytic species of Geotrichum.
Table 3: Zone of inhibition obtained by silver nanoparticles produced by endophytic fungal isolates against standard test bacterial strains.
Zone of inhibition by silver nanoparticles produced by Syncephalis sp. |
||||
Test bacterial strains |
Escherichia coli |
Pseudomonas aeruginosa |
MRSA |
Staphylococcus aureus |
Control |
10 mm |
10 mm |
10 mm |
8 mm |
Test |
14 mm |
13 mm |
14 mm |
12 mm |
Percentage inhibition (%) |
40 |
30 |
40 |
50 |
Zone of inhibition by silver nanoparticles produced by Geotrichum sp. |
||||
Test bacterial strains |
Escherichia coli |
Pseudomonas aeruginosa |
MRSA |
Staphylococcus aureus |
Control |
10 mm |
10 mm |
10 mm |
8 mm |
Test |
18 mm |
12 mm |
16 mm |
12 mm |
Percentage inhibition (%) |
80 |
20 |
60 |
50 |
Values are mean SD of three observations
Fig. 11: Antibacterial activity of silver nanoparticles (1) Silver nitrate (Control); Silver nanoparticles produced by (2) Syncephalis sp. and (3) Geotrichum sp. against test bacteria: (A) MRSA; (B) Staphylococcus aureus; (C) Pseudomonas aeruginosa; (D) Escherichia coli.
Antibacterial enhancing activity of silver nanoparticles in combination with antibiotics
Biosynthesized silver nanoparticles were also evaluated for their ability to enhance the antibacterial activity of some important commercial antibiotics. For this penicillin, methicillin, amoxycillin and ampicillin were used as test antibiotics. The antibacterial enhancing activity was measured as increase in fold area of inhibitory zone.
The result obtained on the efficacy of silver nanoparticles (synthesized by Syncephalis sp. and Geotrichum sp.) in combination with antibiotics revealed an overall increase in fold area of zone of inhibition which indicated the increase in antibacterial potential of all the antibiotics against the test bacterial strains (Figure 12 &13). It was also observed that there was no zone of inhibition in the control region i. e., antibiotics alone and silver nitrate in case of Escherichia coli, Staphylococcus aureus and Pseudomonas aeruginosa.

Fig. 12: Antibacterial activity of silver nanoparticles produced by fungal root endophytic isolate Syncephalis sp. in combination with commercial antibiotics.
[A] Activity against Escherichia coli; 1:P; 2: Met; 3: Amc; 4: Amp; 5: P+ SNPs; 6: Met+SNPs; 7: Amc+SNPs; 8: Amp+SNPs; 9: Silver nitrate control.[B] Activity against MRSA; 1:Amp; 2: Amc; 3: P; 4: Met; 5: Amp+ SNPs; 6: Amc+SNPs; 7: Met+SNPs; 8: P+SNPs; 9: Silver nitrate control.[C] Activity against Pseudomonas aeruginosa; 1:Met; 2: Amc; 3: P; 4: Amp; 5: P+ SNPs; 6: Amc+SNPs; 7: Met+SNPs; 8: Amp+SNPs; 9: Silver nitrate control.[D] Activity against Staphylococcus aureus; 1:Amp; 2: Amc; 3: Met; 4: P; 5: P+ SNPs; 6: Met+SNPs; 7: Amc+SNPs; 8: Amp+SNPs; 9: Silver nitrate controlt
However, the maximum increase in fold area of inhibition (13.6 fold increase) was obtained against Escherichia coli when methicillin was combined with the silver nanoparticle produced by Syncephalis sp. (Table 4).While in case of Geotrichum sp. the maximum increase in fold area was obtained against Escherichia coli when methicillin and amoxicillin were combined with silver nanoparticles (Table 5).
Table 4: Antibacterial activity of antibiotic alone and antibiotic in combination with silver nanoparticles synthesized by Syncephalis sp.
Test bacterial strain |
Escherichia coli |
MRSA |
Pseudomonas aeruginosa |
Staphylococcus aureus |
||||||||
Test |
Ab |
Ab+ AgNp |
[B]²-[A]² /[A]² |
Ab |
Ab+ AgNp |
[B]²-[A]² /[A]² |
Ab |
Ab+ AgNp |
[B]²-[A]² /[A]² |
Ab |
Ab+ AgNp |
[B]²-[A]² / [A]² |
Penicillin |
- |
22 mm |
12.44 |
- |
20m |
10.1 |
- |
18 mm |
8 |
- |
16 mm |
6.1 |
Methicillin |
- |
23 mm |
13.6 |
8 mm |
19 mm |
4.64 |
- |
15 mm |
5.25 |
- |
10 mm |
1.7 |
Amoxicillin |
- |
22 mm |
12.4 |
5 mm |
10 mm |
3 |
- |
16 mm |
6.1 |
- |
12 mm |
3 |
Ampicillin |
- |
24 mm |
15 |
- |
9 mm |
1.25 |
- |
16 mm |
6.1 |
- |
12 mm |
3 |
Values are mean SD of three observations.
Ab: Antibiotic; Ab + AgNp: Antibiotic in combination with silver nanoparticle, Where [A] and [B] denotes Ab alone and Ab+ silver nanoparticle produced respectively and the increase in fold area of inhibition is shown by [B]²-[A]²/[A]2.
|
 |
| A | B |
|
|
| C | D |
Fig. 13: Antibacterial activity of silver nanoparticles produced by fungal root endophytic isolate Geotrichum sp. in combination with commercial antibiotics.
[A] Activity against Escherichia coli; 1: Met; 2: Amp; 3: P; 4: Amc; 5: Met+ SNPs; 6: P+SNPs; 7: Amp+SNPs; 8: Amc+SNPs; 9: Silver nitrate control.[B] Activity against MRSA; 1:Met; 2: P; 3:Met+SNPs; 4: Amp; 5: Amc; 6: Amc+SNPs; 7: Amp+SNPs; 8: P+SNPs; 9: Silver nitrate control.[C] Activity against Pseudomonas aeruginosa; 1:Met; 2: Amp; 3: Amc; 4: P; 5: Amc+ SNPs; 6: Amp+SNPs; 7: Met+SNPs; 8: P+SNPs; 9: Silver nitrate control.[D] Activity against Staphylococcus aureus; 1:Met; 2: P; 3: Amc; 4: Amp; 5: Amc+ SNPs; 6: Amp+SNPs; 7: P+SNPs; 8: Met+SNPs; 9: Silver nitrate control.
Table 5: Antibacterial activity of antibiotic alone and antibiotic in combination with silver nanoparticles synthesized by Geotrichum sp.
Test bacterial strain |
Escherichia coli |
MRSA |
Pseudomonas aeruginosa |
Staphylococcus aureus |
||||||||
Test |
Ab [A] |
Ab+ AgNp |
[B]²-[A]² /[A]² |
Ab |
Ab+ AgNp |
[B]²-[A]² /[A]² |
Ab |
Ab+ AgNp |
[B]²-[A]² /[A]² |
Ab |
Ab+ AgNp |
[B]²-[A]² / [A]² |
Penicillin |
- |
21 mm |
11.25 |
22 mm |
24 mm |
0.19 |
- |
14 mm |
4.4 |
- |
8 mm |
0.7 |
Methicillin |
- |
23 mm |
13.69 |
22 mm |
35 mm |
1.53 |
- |
15 mm |
5.25 |
- |
18 mm |
8 |
Amoxicillin |
- |
23 mm |
13.69 |
21 mm |
25 mm |
0.41 |
- |
15 mm |
5.25 |
- |
12 mm |
3 |
Ampicillin |
- |
22 mm |
12.4 |
22 mm |
26 mm |
0.39 |
- |
16 mm |
6.1 |
- |
10 mm |
1.7 |
Values are mean SD of three observations, Ab: Antibiotic; Ab + AgNp: Antibiotic in combination with silver nanoparticle, Where [A] and [B] denotes Ab alone and Ab+ silver nanoparticle produced respectively and the increase in fold area of inhibition is shown by, [B]²-[A]²/[A]2.
CONCLUSION
Nanotechnology is a rapidly growing field with its applications in science and technology for the purpose of manufacturing new materials at the nanoscale level. By the use of nanotechnology we can manipulate the properties of nanomaterials according to our requirements. Nanoparticles can be synthesized by chemical and physical methods but due to certain disadvantages like being expensive and release of hazardous compounds, there is a need for alternative safer, efficient and economic methods. In this regard, the green technology of nanoparticle synthesis is the most preferred method now a days. Among biological means of nanoparticles synthesis, the fungi have got certain advantages by virtue of their physiological and morphological characteristics which have made the process of nanoparticle biosynthesis inexpensive and eco-friendly. Therefore, there is a need to screen out fungal isolates from diverse biotopes for their nanoparticles synthesizing capabilities which in turn may prove beneficial for various applications including medical as well as industrial.
CONFLICT OF INTERESTS
Declared none.
REFERENCES
- Mansoori GA. Principles of Nanotechnology-Molecular Based Study of Condensed Matter in Small Systems, World Scientific Pub. Co, Hackensack, NJ; 2005.
- Tran QH, Nguyen VQ, Le AT. Silver nanoparticles: synthesis, properties, toxicology, applications and perspectives. Adv Nat Sci Nanosci Nanotechnol 2013;4:1-20.
- Ingale AG, Chaudhari AN. Biogenic synthesis of nanoparticles and potential applications: An eco friendly approach. J Nanomed Nanotechol 2013;4:1-7.
- S Mann: Biometric Materials Chemistry, VCH Publishers; 1996.
- Bacon CW, Hinton DM, Porter JK, Glenn AE, Kuldau G. Fusaric acid, a Fusarium verticillioides metabolite, antagonistic to the endophytic biocontrol bacterium Bacillus mojavensis. Can J Bot 2004;82:878-85.
- Hallmann J, Berg G, Schulz B. Isolation procedures for endophytic microorganisms, Springer Brelin Heidelberg. New York; 2007.
- Tieghem V, Le MPG. Recherches sur les mucorinees. Ann Sci Nat Bot 1873;17:261-399.
- Kurtzman CP, Fell JW, The yeasts: a taxonomic study, Amsterdam, Fourth Edition; 1998.
- Hemanth NKS, Gaurav K, Karthik L, Bhaskara RKV. Extracellular biosynthesis of silver nanoparticles using the filamentous fungus Penicillium sp. Arch Appl Sci Res 2010;2:161-7.
- Midolo PD, Turnidge J, Lambert JR, Bell JM. Validation of a modified Kirby-Bauer disk diffusion method for Metronidazole susceptibility testing of Helicobacter pylori. Diagn Microbiol Infect Dis 1995;21:135-40.
- Bauer AW, Kirby WM, Sherris JC, Turck M. Antibiotic susceptibility testing by a standardized single disk method. Am J Clin Pathol 1966;36:493-6.
- Birla SS, Tiwari VV, Gade AK, Ingle AP, Yadav AP, Rai MK. Fabrication of silver nanoparticles by Phoma glomerata and its combined effect against Escherichia coli, Pseudomonas aeruginosa and Staphylococcus aureus. Lett Appl Microbiol 2009;27:76-83.
- Selvi KV, Sivakumar T. Isolation and characterization of silver nanoparticles from Fusarium oxysporum. Int J Curr Microbiol App Sci 2012;1:56-62.